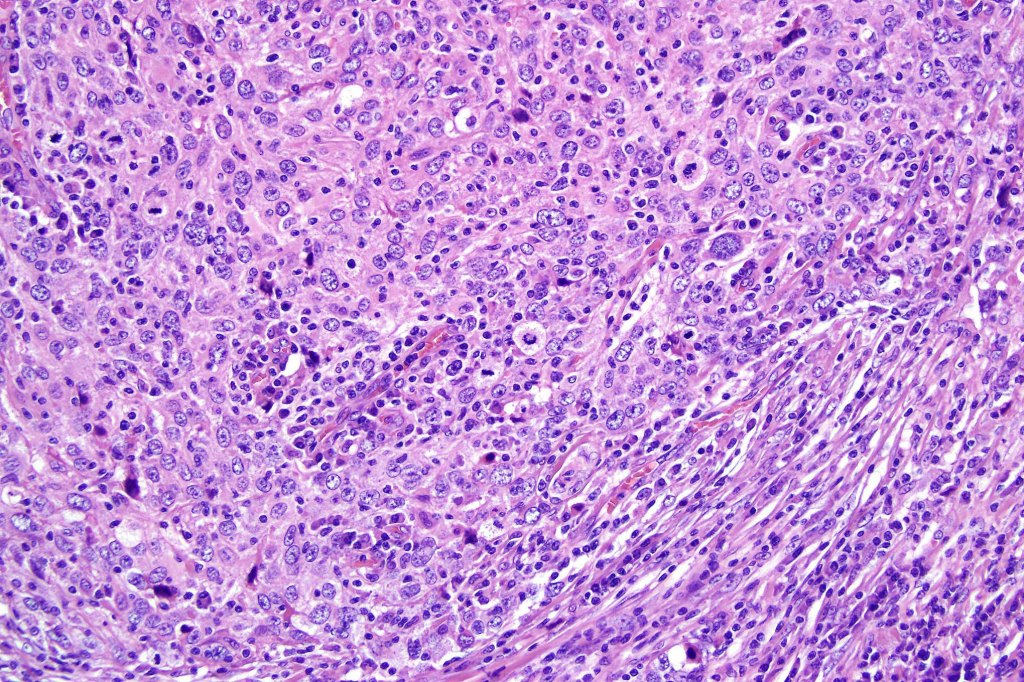
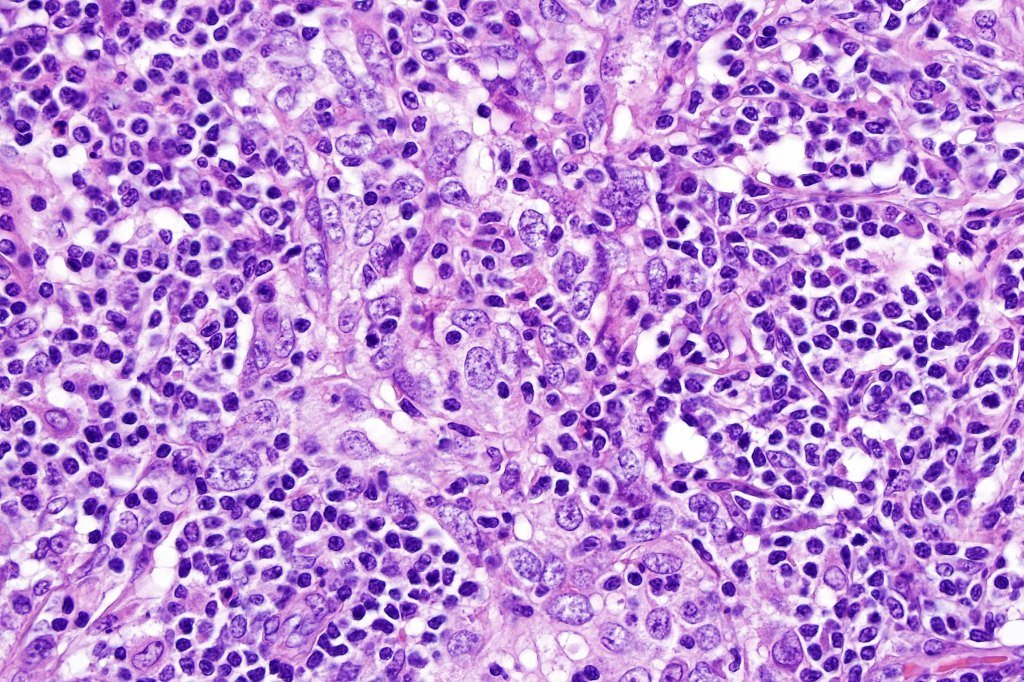
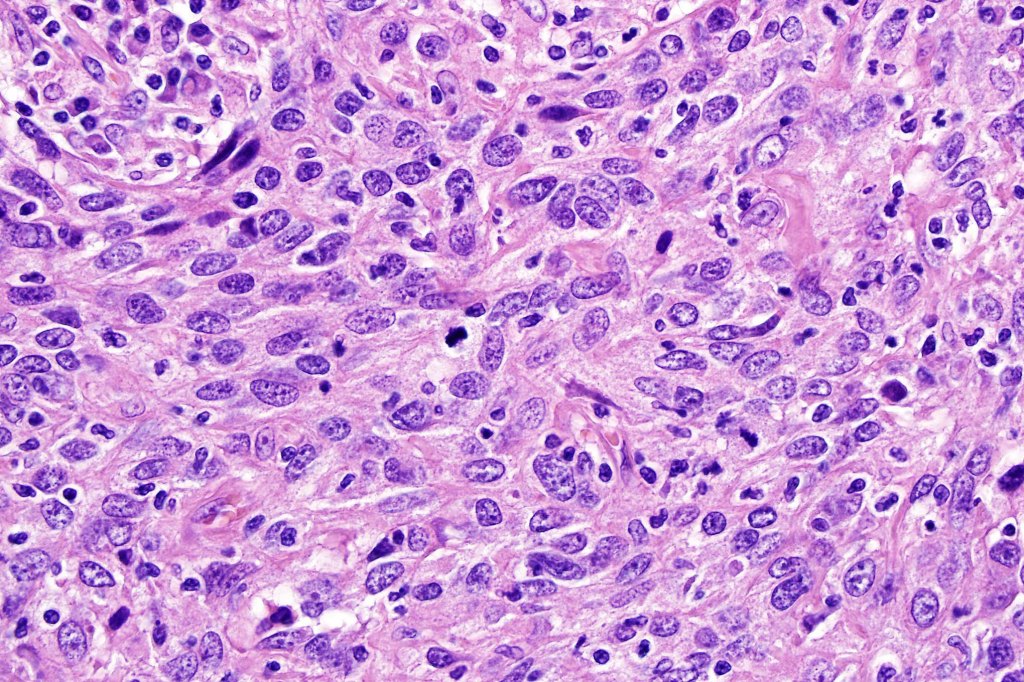
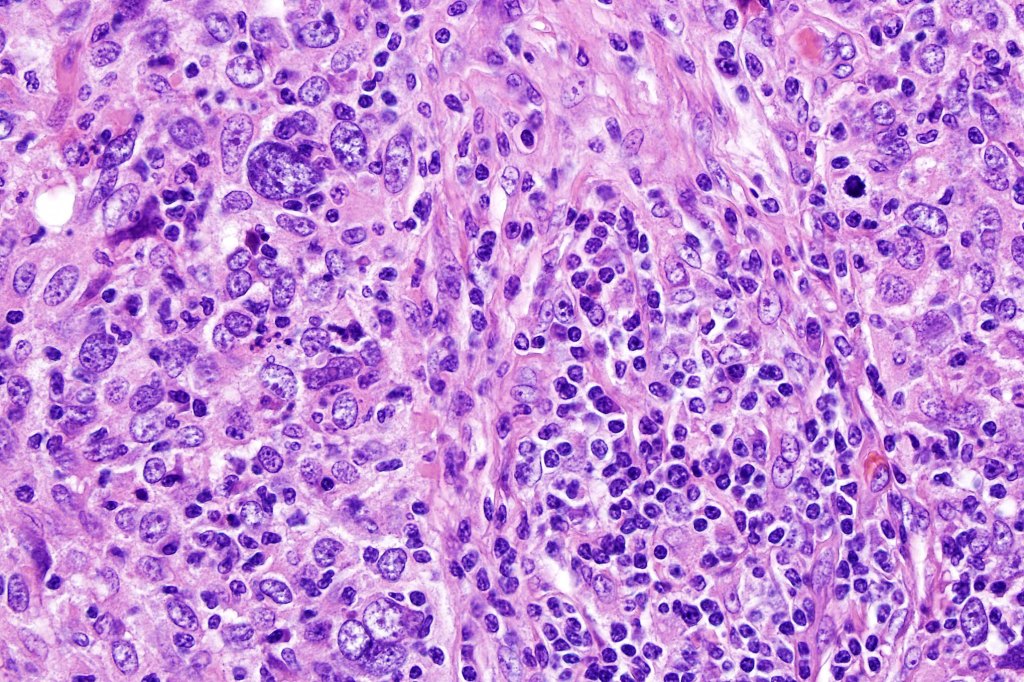

Clinical features
•Extremely rare cutaneous tumor
•Variably considered a variant of squamous cell carcinoma or an entity sui generis representing the cutaneous equivalent of nasopharyngeal lymphoepithelioma-like carcinoma; lastly is the possibility of an adnexal carcinoma
•Head & neck with predilection for sun-damaged skin; solitary flesh colored or erythematous, firm nodule or plaque
•Exceptionally presents elsewhere e.g., trunk & arm
•Elderly (39-96 years; mean 70 years)
•M=F
•Low grade with recurrence (10%) and very rare metastasis
Histological features
•Dermal generally circumscribed tumor nodule (less often it may show an infiltrative border)
•Syncytial epithelial component in nests, cords or sheets surrounded by an intense lymphoplasmacytic infiltrate
•Epithelial cells are large with abundant cytoplasm and vesicular nuclei with conspicuous nucleoli
•Marked mitotic activity, variable pleomorphism
•Absence of an epidermal connection
•Variable perineural infiltration
•Variable adnexal differentiation (follicular, sebaceous & eccrine)
•Very exceptional squamous differentiation described (1 case)
•AE1/AE3, CK5/6, p63, p40, EMA +ve
•Inflammatory infiltrate- admixture of both CD20-B-cell & CD3-T-cells
.ISH for EBV-ve

Differential diagnosis
In the first instance, metastasis from a nasopharyngeal or other primary site (salivary glands, lung, stomach, thymus, larynx, cervix and bladder) must be excluded. Negative in situ hybridisation for EBV is obviously important discriminant. Lymphadenoma cutis is an occasional differential diagnosis. In the latter, the epithelial nests show peripheral palisading and there is no significant cytological atypia or mitotic activity. Lymphoma may somtimes enters the differential diagnosis but immunohistochemistry to display the epithelial component will make the distinction.
Leave a comment